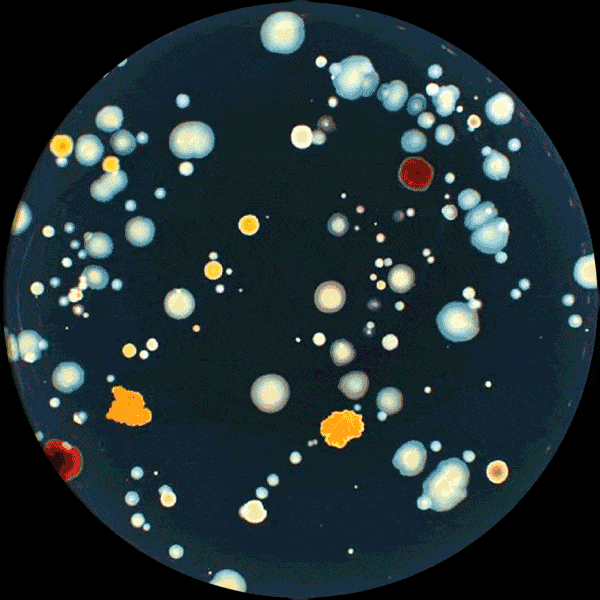

SCAN 1200 (CONTADOR COLONIA)
Scan 1200 es un contador automático de colonias de alta definición. Se adapta a todos los medios y cuenta en un sólo click todas las colonias presentes, hasta las más pequeñas. Asegura gran precisión y excelente reproducibilidad. Las imágenes y los resultados son guardados automáticamente. El Scan 1200 es también un lector de zonas de inhibición.
- Tamaño mínimo de la colonia detectada: 0.05 mm
- Cámara: 1.2 megapíxels - zoom x 28
- Recuento en placas de Petri de Ø 55 - 90 mm
- Recuento de siembras en modo en masa, en superficie, Spiral, círculo
- Recuento en agar cromogénico, PetriFilmTM, MC-media PadsTM, Compact DryTM, Easy PlateTM, membranas de filtración
- Lector de zonas de inhibición
Amplia gama de lectura
El Scan 1200 permite la lectura en placas de Petri de Ø 55 - 90 mm y funciona con una gran variedad de medios y soportes. El Scan 4000 es también un lector de zonas de inhibición en placas de Petri redondas.
Precisión y repetibilidad
El recuento de una placa de Petri es largo, tedioso y puede variar de una persona a otra.
El Scan 1200 permite contar hasta 1000 colonies en 1 segundo de manera constante y repetible. La precisión del recuento alcanza el 98%. El tamaño mínimo de la colonia detectada es de 0.05 mm.
21 CFR Part 11 incluido
El software Scan cumple con las recomendaciones de la FDA, incluyendo el audit trail y la seguridad de los resultados.
La gestión de las cuentas de usuario, integrada en el software, permite la creación de 5 niveles de derechos. El supervisor-administrador tiene todas las funciones, mientras que las demás funciones están sujetas a ciertos derechos. La administración de contraseñas asegura las cuentas de los usuarios.
Tecnología de iluminación campo oscuro « Dark Field »
Gracias a la tecnología de iluminación de campo oscuro, las colonias son fáciles de contar. No causa fatiga a los ojos del analista.
Garantice la trazabilidad con dataLink
Con dataLink, puede realizar un seguimiento de la muestra desde la siembra hasta el conteo automático de colonias.
Personalice la etiqueta que se pegará en el borde de la placa de Petri. A continuación, se optimiza el recuento de colonias.